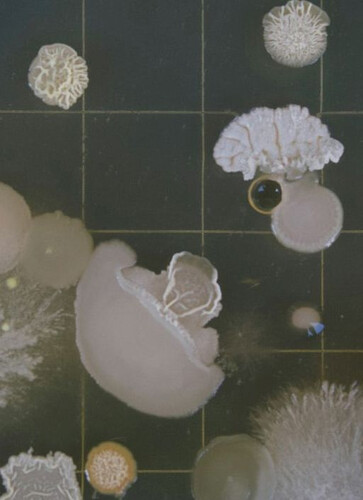
Biotomata - Обложка

Biotomata
|
Год выпуска:
2025
Жанр: RPG Разработчик: Talos0248 Издатель: Talos0248 Платформа: PC Тип издания: Бесплатная игра Таблетка: Вшита Новая инкрементальная игра представленная в минималистичном научно-фантастическом ключе. На этот раз, разработчики решили совместить элементы классических стратегий, головоломку и полноценный сюжет, где игрокам предстоит взять под контроль саму эволюцию. Говоря простыми словами, в "Biotomata" под их контролем окажется таинственное одноклеточное существо, которое нам предстоит превратить в нечто гигантское и крайне разрушительное. Конечная цель - обрести невероятную мощь и поглотить весь мир! Впрочем, как всё будет выглядеть на практике, зависит исключительно от вас, ведь в игре предусмотрено двенадцать полноценных финалов! Системные требования:
Скачать Biotomata торрентОС: Windows 10, 11 (64-bit) Размер игры: [107 MB] | |
| 49 | 9 Как скачать? |
Интересные Приключения
| Всего комментариев: 0 | |